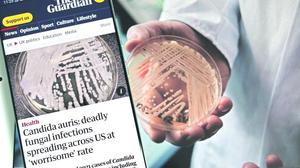

Más leídas

Actualidad | Pág. 2
En 2022 cayeron los metros construidos, pero aumentaron los permisos

Actualidad | Pág. 8
Humor

Estrellas | Pág. 18
Martín Acertijo, el freestyler que llegó a mezclar trap y cueca brava

Servicios | Pág. 13
¿Cómo se contagia y se trata el hongo Candida Auris?

Deportes | Pág. 12
"(Lo de hacer la cama) es falso, estamos juntos en las buenas y las malas"

Deportes | Pág. 12
Falcón criticó la ausencia de hinchas albos para el sábado

Deportes | Pág. 12
Andía y el duelo azul ante Audax Italiano: "Es trascendental"
Deportes | Pág. 11
Comienza nueva edición del tour Entel Reutiliza por Chile en la Región de Arica

Deportes | Pág. 10
Trasandino evalúa positivamente su duelo en Copa Chile
Actualidad | Pág. 9
Editorial
Actualidad | Pág. 9
Desde el morro

Actualidad | Pág. 9
Comentarios

Actualidad | Pág. 9
De nuestro archivo

Actualidad | Pág. 8
Zoom

Actualidad | Pág. 8
Tablas de mareas
Actualidad | Pág. 8
Farmacia de turno

Actualidad | Pág. 3
En Santo Tomás realizaron "mechoneo solidario"
Actualidad | Pág. 8
Emergencias
Actualidad | Pág. 8
Colegio de Periodistas y libertad de prensa
Actualidad | Pág. 8
Armas
Actualidad | Pág. 7
40 horas partirán de modo gradual y con la opción de trabajar 4 días a la semana

Actualidad | Pág. 6
Transeúntes evalúan positivamente acciones preventivas en 21 de Mayo

Actualidad | Pág. 6
Operación Ossa: Cae una banda dedicada al tráfico de migrantes

Actualidad | Pág. 6
12 años de cárcel para profesor que abusó de 3 alumnas

Actualidad | Pág. 5
Arica fue incluida en Plan Especial "Calles sin Violencia"

Actualidad | Pág. 4
Más de 38 mil cruces a Tacna hubo en 3 días de festivo

Actualidad | Pág. 4
Fin de semana largo: 10% de buses fiscalizados fue multado

Actualidad | Pág. 4
Académicos de Chile, Perú y Bolivia en evento

Actualidad | Pág. 3
Servicio de pediatría del Hospital de Arica cuenta con aula hospitalaria

Actualidad | Pág. 3
Informan alza de enfermedades respiratorias en niños

Estrellas | Pág. 19
Realizarán talleres de conservación sostenible para niños y adolescentes